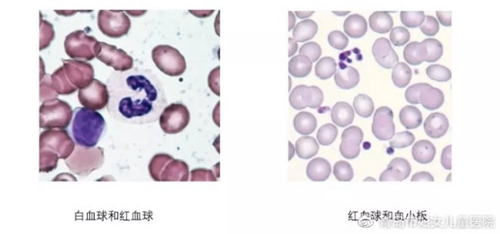
c2ef7eaaly1gwch9zankgj20id08maan.jpg

健康青島科普資源庫丨骨髓移植小科普
發(fā)布時間:2021/11/14 9:20:20??/??瀏覽量:??/??【關閉】
骨髓移植,即造血干細胞移植,是通過靜脈輸注造血干、祖細胞,重建患者正常造血與免疫系統(tǒng),治療一系列疾病的方法。聽到骨髓移植這個概念,老百姓們都比較害怕。事實上,在這個信息高速化時代,網絡上仍有許多有關骨髓移植不恰當甚至錯誤的說法,大家對于骨髓移植的了解其實并不深。那么,骨髓移植到底是什么?讓我們一起來了解一下吧。
1. 什么是骨髓?
骨髓—是骨頭中間位于中心部的膠狀造血組織,白細胞、紅細胞、血小板就是骨髓持續(xù)不斷制造出來的。骨髓中含有成為這些細胞源頭的造血干細胞。紅細胞搬運氧氣,白細胞阻擊外部侵入的細菌,血小板起到止血的作用。這些血細胞,由骨髓中的造血干細胞制造出來并送到血液當中。
2.什么是造血干細胞移植?
造血干細胞移植是針對患有白血病、再生障礙性貧血、骨髓增生異常綜合征、免疫缺陷病、惡性腫瘤等疾病的治療手段,把這些疾病中骨髓里的“壞細胞”置換成健康的細胞?!霸煅杉毎浦病边@個詞語聽起來還不太習慣,以前是指骨髓移植,現在除了骨髓以外也可以使用外周血和臍帶血(從新生兒、小嬰兒臍帶提取的血液)來進行移植,所以用這個叫法??梢蕴峁┙】档脑煅杉毎娜恕覀兎Q為“捐獻者”。骨髓移植是使用專用的針刺入“捐獻者”皮膚,將通過注射器從“捐獻者”骨髓中吸取“骨髓液”通過靜脈點滴的方式注入患兒體內。外周血干細胞移植和臍帶血干細胞移植也是通過同樣的方式來進行治療。
3.什么是 HLA?
同紅細胞的血液分類分為 A、B、AB、O型一樣,白細胞也同樣具有血液分類,白細胞的血型稱為 HLA,也被稱為人體白細胞抗原或者組織適合抗原,HLA 分為A座、B 座、C座、DR座、DP 座、DQ座等乃至更加細致的分類,每種都有數種及數十種分類,組合起來的話有數萬種類型。

HLA 的遺傳信息存在于第六個染色體內,而第六個染色體從父母那里各繼承一個,所以同一父母生出來的小朋友,存在 4 種 HLA 的類型,因此兄弟姐妹中 HLA 一致的概率應該是四個人當中只有 1 人一致。HLA 配型一致一般是指 A、B、DR這三種類型的 6 個抗原全部一致,其中有一個不一致的情況下作為次選方法進行骨髓移植。除 HLA 的配型檢查以外,還要做患者和捐獻者之間的適合性檢查,稱為 MLC(淋巴球細胞混合培養(yǎng))檢查,兩者的淋巴球相合一致的話為陰性,不一致的話為陽性,因此 HLA 一致且 MLC為陰性是最適合的移植類型,也就是我們經常提到的“全相合”。
4.關于移植前的準備
準備接受骨髓移植的患兒大約在骨髓移植前 1 個月住院,接受身體評估,評估能否耐受大量的放射線照射和免疫抑制劑的治療,比如評估患者的心功能、肝功能和腎功能,或者檢查身體哪里有可能成為感染源或者感染灶(齲齒、鼻竇炎、或者某些陳舊性病變),另外移植前 2- 3 周可以進行實際的無菌倉體驗(滿倉情況下,無法進行體驗,敬請諒解),入倉體驗時的身體情況比較樂觀,容易讓人疏忽大意,但入倉體驗對實際進入無菌倉幫助很大,所以入倉體驗時需要好好學習。而骨髓移植前后,需要進行多次靜脈點滴—輸血—采血等操作,這種反復“扎針”的有創(chuàng)操作對身體損傷極大,所以進行骨髓移植前通常會將稱作“靜脈中心導管”的管道通過頸部或者胸部留置在體內相對粗的血管中。
5.移植前的預處理以移植為目的的預處理,一般會在移植前 7- 10 天開始,不管是基礎疾病產生的“壞細胞”還是健康的造血干細胞都會被徹底摧毀,通俗來講,預處理就是骨髓移植前給患者做大劑量化療,以殺滅腫瘤細胞,抑制免疫,有利于造血于細胞植入。
6.骨髓移植對于捐獻者有何影響?
由于國內主要是采集外周血,遠期來講對身體基本是沒有影響的,但短期會因為需要注射促進白細胞生長的針劑,以便動員骨髓內的干細胞釋放到外周血中;并且連續(xù)注射 5天左右,以便后續(xù)采集。而細胞采集過程較長大概為 4- 5 小時,會發(fā)生一定疲勞感,但基本很快就會恢復。
7. 對于骨髓移植,大家還有哪些認識誤區(qū)?
誤區(qū)有很多。例如,排異直接導致死亡率高嗎?答案是否定的,隨著醫(yī)療技術的提高,出現排異的概率越來越小,因排異直接導致死亡的情況也越來越少。另外,骨髓移植后能長期生存嗎?答案是肯定的。骨髓抑制的目的是讓患者康復,參加工作,回歸正常的社會生活,恢復良好者基本同健康人一樣。
骨髓移植可以為更多的病患帶來福音,讓飽受病痛的患者回歸正常生活,希望大家可以正確認識骨髓移植,而不是對它諸多誤解,愛灑人間,生命因您而精彩。


